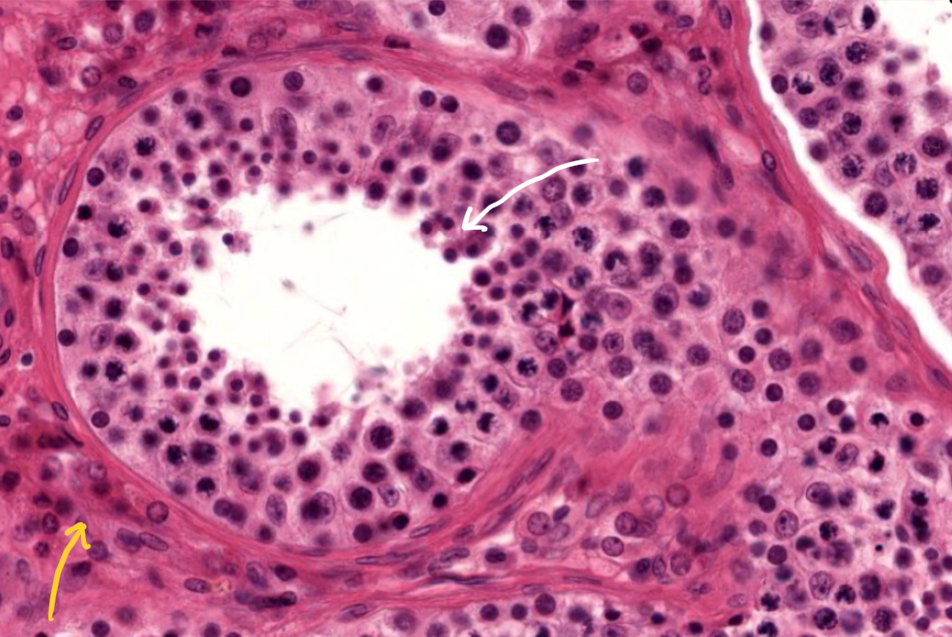
<p>What’s in yellow?</p>

1/71
Looks like no tags are added yet.
Name | Mastery | Learn | Test | Matching | Spaced |
|---|
No study sessions yet.

What is this?
Fibroblast from deep connective tissue

What is this?
Endomysium of skeletal muscle tissue

What is this?
Perimysium of skeletal muscle tissue

What is this?
Epimysium of skeletal muscle tissue

What’s in yellow?
Osteon

What’s in red?
Lamella

What’s in green?
Lacunae

What’s in blue?
Central canal

What is this?
Endoneurium of peripheral nerve

What is this?
Perineurium of peripheral nerve

What is this?
Epineurium of peripheral nerve

What is this?
Testis

What’s in white?
Sertoli cells of testis
What’s in yellow?
Leydig cells of testis

What is this?
Ovary

What’s in yellow?
Thecal cells of ovaries

What’s in green?
Antrum

What’s in brown?
Corona radiata

What’s in blue?
Oocyte

What is this?
Uterus

What’s in orange?
Functional layer of uterus

What’s in blue?
Basal layer of uterus

What’s in black?
Myometrium

What is this?
Bladder

What is this?
Transitional epithelium (umbrella cells) of bladder

What is this?
Esophagus

What’s in red?
Muscular is external of the esophagus

What’s in orange?
Submucosa

What’s in green?
Mucosa

What’s in blue?
Esophageal glands

What is this?
Spleen

What’s in yellow?
Trabeculae of spleen

What’s in red?
Red pulp of spleen

What’s in blue?
White pulp of spleen

What is this?
Pancreas

What is this?
Acini of pancreas

What is this?
Kidney

What’s in yellow?
Distal convoluted tubule of kidney

What’s in green?
Proximal convoluted tubule of kidney

What’s in orange?
Renal corpuscle of kidney

What’s in red?
Medulla of kidney

What’s in black?
Loop of henle in kidney

What’s in yellow?
Vasarecta of kidney

What is this?
Nephron

What’s in orange
Renal corpuscle of nephron

What’s in yellow?
Bowman’s capsule

What’s in blue?
Bowman’s space

What’s in green?
Glomerulus

What’s in black?
Parietal layer

What’s in red?
Vasarecta

What’s in yellow?
Collecting duct

What’s in blue?
Nephronic loop

What is this?
Liver

What’s in black?
Central vein of liver

What’s in yellow?
Lines-cords of hepatocytes

What is this?
Sinousoid

What is this?
Duodenum

What is this?
Brunners glands of duodenum
What is this?
Vili of duodenum

What is this?
Jejunum

What is this?
Vili of jejunum

What is this?
Ilieum

What is this?
Intestinal crypt of ilieum

What is this?
Vili of ilieum

What is this?
Peyer’s patches of ilieum

What is this?
Colon

What’s in yellow?
Crypt of colon

What’s in blue?
Goblet cell of colon

What is this?
Fundic of stomach

What’s in black?
Mucosa of stomach

What’s in blue?
Gastric pit of stomach

What is this?
Submucosa of stomach